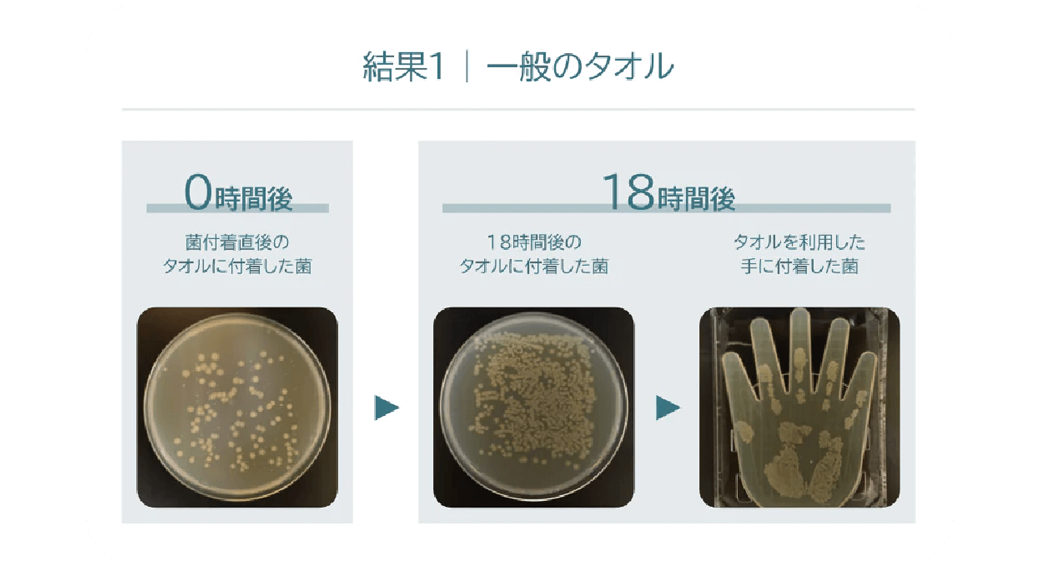
files/LP-img1008_1.png
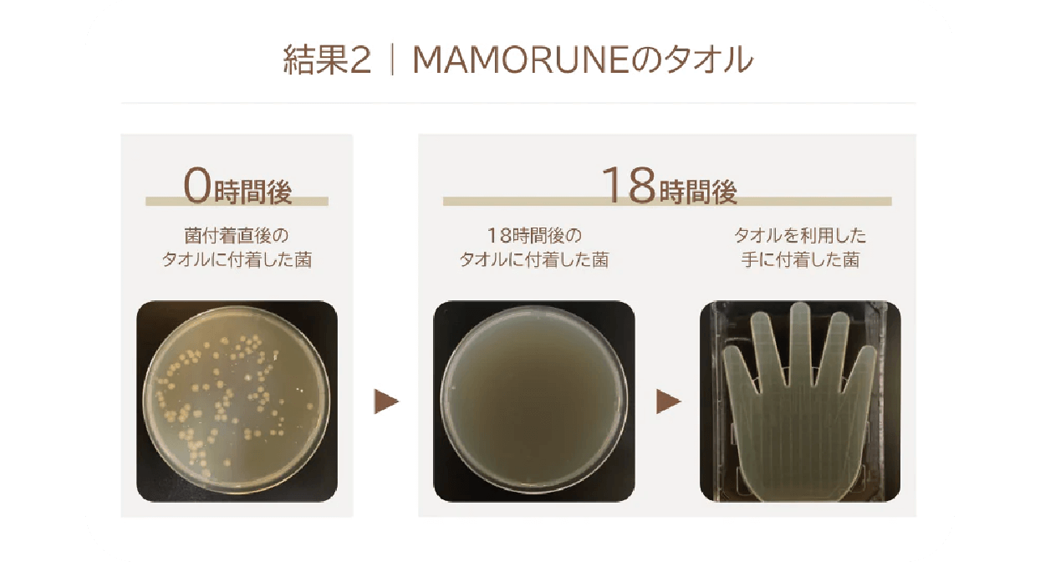
files/lp-img1008_2.png

LPページ-MAMORUNE Premium
タイトルが入ります
説明文が入ります
LPページ-MAMORUNE Premium
タイトルが入ります
説明文が入ります
- 抗菌
消臭 バイバイばいきん!
1年間ずっと清潔キープ!
毎日使うタオルだからこそ、安心して清潔を保ちたい。お風呂上がりや運動後、家族みんなで使うタオルも、これなら常にクリーンな状態をキープできます。 長時間の使用でも、嫌なニオイの発生を防ぎ、柔らかな肌触りをキープ。 抗菌と消臭効果が続くから、忙しい毎日の中でもお手入れが簡単。 日常生活をより快適に、そして衛生的にサポートする、頼れる一枚です。

-

あなたのタオルは大丈夫?
⼀度でも⼿を拭いたタオルは、
菌だらけでした。⼀般的なタオルは、⼀度でも⼿や顔を拭くと、
⼿や顔に付いていた菌がタオルに移り
知らない間に増殖し続けてしまいます。
MAMORUNEは、優れた抗菌効果で菌の増殖を防ぐ、
安⼼して使える本当に清潔なタオルです。
-
においバスター!
90%以上の分解パワー!
-
ヘビロテOK!抗菌も消臭も
1年後も変わらぬチカラ!
-
赤ちゃんもニコニコ♪
安心の350チェッククリア!
お得な情報配信中!
お友達登録はこちら >MAMORUNE PREMIUM STANDARD
MAMORUNEの菌の増殖を抑え臭いの発生を防ぐ機能に、臭い成分を分解する機能をプラスしました。
MAMORUNE PREMIUMで臭いを気にしない生活へ。


 LINE お友達登録
LINE お友達登録